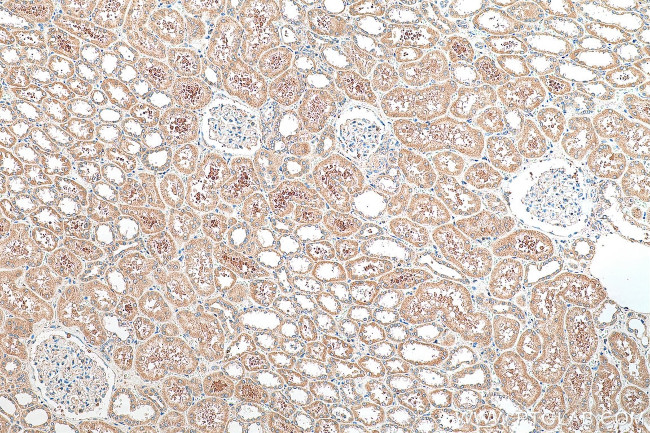
SERINC3 Antibody in Immunohistochemistry (Paraffin) (IHC (P))
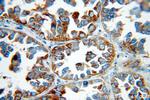
SERINC3 Antibody in Immunohistochemistry (Paraffin) (IHC (P))

Search
Proteintech
SERINC3 Polyclonal Antibody
{{$productOrderCtrl.translations['antibody.pdp.commerceCard.promotion.promotions']}}
{{$productOrderCtrl.translations['antibody.pdp.commerceCard.promotion.viewpromo']}}
{{$productOrderCtrl.translations['antibody.pdp.commerceCard.promotion.promocode']}}: {{promo.promoCode}} {{promo.promoTitle}} {{promo.promoDescription}}. {{$productOrderCtrl.translations['antibody.pdp.commerceCard.promotion.learnmore']}}
产品信息
20267-1-AP
种属反应
宿主/亚型
分类
类型
抗原
偶联物
形式
浓度
规格
纯化类型
保存液
内含物
保存条件
运输条件
产品详细信息
The antibody is specific to SERINC3.
靶标信息
TDE1, tumor differentially expressed protein 1, is a multi-pass membrane protein also known as serine incorporator 3. Also found on the membranes of the Golgi apparatus within cells, TDE1 is highly expressed in neuronal populations but is also found in thymus, kidney, liver and testis. Expression levels of TDE1 in tumors can be as much as tenfold the amount found in normal tissue of the same type. This increased expression implicates TDE1 as being involved in the cellular transformation from normal to malignant tissue. It is believed TDE1 contributes to oncogenesis by partially protecting cells from serum starvation and etoposide-induced apoptosis. The mechanism through which TDE1 protects cells is poorly understood, but may involve aberrant methylation of TDE1 complexes.
仅用于科研。不用于诊断过程。未经明确授权不得转售。
篇参考文献 (0)
生物信息学
蛋白别名: AIGP-1; Axotomy-induced glyco/Golgi protein 1; Axotomy-induced glycoprotein 1; Diff33; Membrane protein TMS-1; Serine incorporator 3; tumor differentially expressed 1; Tumor differentially expressed protein 1; unnamed protein product
基因别名: AA959945; AA960047; AIGP1; DIFF33; SBBI99; SERINC3; TDE; TDE1; TMS-1; Tms1
UniProt ID: (Human) Q13530, (Mouse) Q9QZI9
Entrez Gene ID: (Human) 10955, (Mouse) 26943, (Rat) 296350